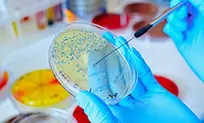

Pioneering Herbal Health Solutions
through Advanced R&D
About BVG Life Sciences LimitedIntegrating Tradition with Modern Science for Holistic Wellness
About Our R&D Unit
BVG Life Sciences Limited’s R&D unit is a leader in the research, development, and commercialization of herbal health products. Rooted in the Indian traditional medicinal system, we integrate these time-honored practices with cutting-edge scientific techniques to deliver innovative health solutions.
Our Mission
Our motto, Inspired by Nature and Proven by Science, drives us to enhance our knowledge with innovative approaches. We focus on traditional medicine, herbal pharmaceuticals, nutraceuticals, phytochemicals, and agriculture, ensuring efficacy and safety through a holistic approach.
Our Research Focus
We undertake multifaceted research activities, combining traditional wisdom with modern science. Our integrative approach ensures the development of natural products and technologies for both human health and agriculture without compromising classical principles.
Our R&D Capabilities
BVGLSL’s state-of-the-art R&D lab is equipped to conduct advanced research in various life science disciplines. We adhere to strict guidelines and protocols for all scientific studies, ensuring the highest quality of research and development.
Become a Part of Our Innovative Team!
Our Achievements

85 +
Health OPD Products

6500 +
Molecular Phytochemical Evaluation

40 +
National and International Collaborations

300000 +
Individuals Benefited

100 +
Technical and Scientific Members
Our Products
We offer a diverse range of products focused on health and wellness, cosmeceuticals, and classical formulations.
-
Quick view
Hair Care Kit
₹1,058.00Original price was: ₹1,058.00.₹952.00Current price is: ₹952.00. -
Quick view
Skin Care Kit
₹1,058.00Original price was: ₹1,058.00.₹952.00Current price is: ₹952.00. -
Quick view
Winter Wellness Kit
₹344.00Original price was: ₹344.00.₹309.00Current price is: ₹309.00. -
Quick view
Rhumanosa Tablet
₹510.00Original price was: ₹510.00.₹484.00Current price is: ₹484.00. -
Quick view
Stress Management Kit
₹1,085.00Original price was: ₹1,085.00.₹976.00Current price is: ₹976.00. -
Quick view
Pain & Inflammation Management Kit
₹807.00Original price was: ₹807.00.₹726.00Current price is: ₹726.00.
Customer Feedback
Positive feedback from customers, including doctors and practitioners, underscores our commitment to quality and efficacy.